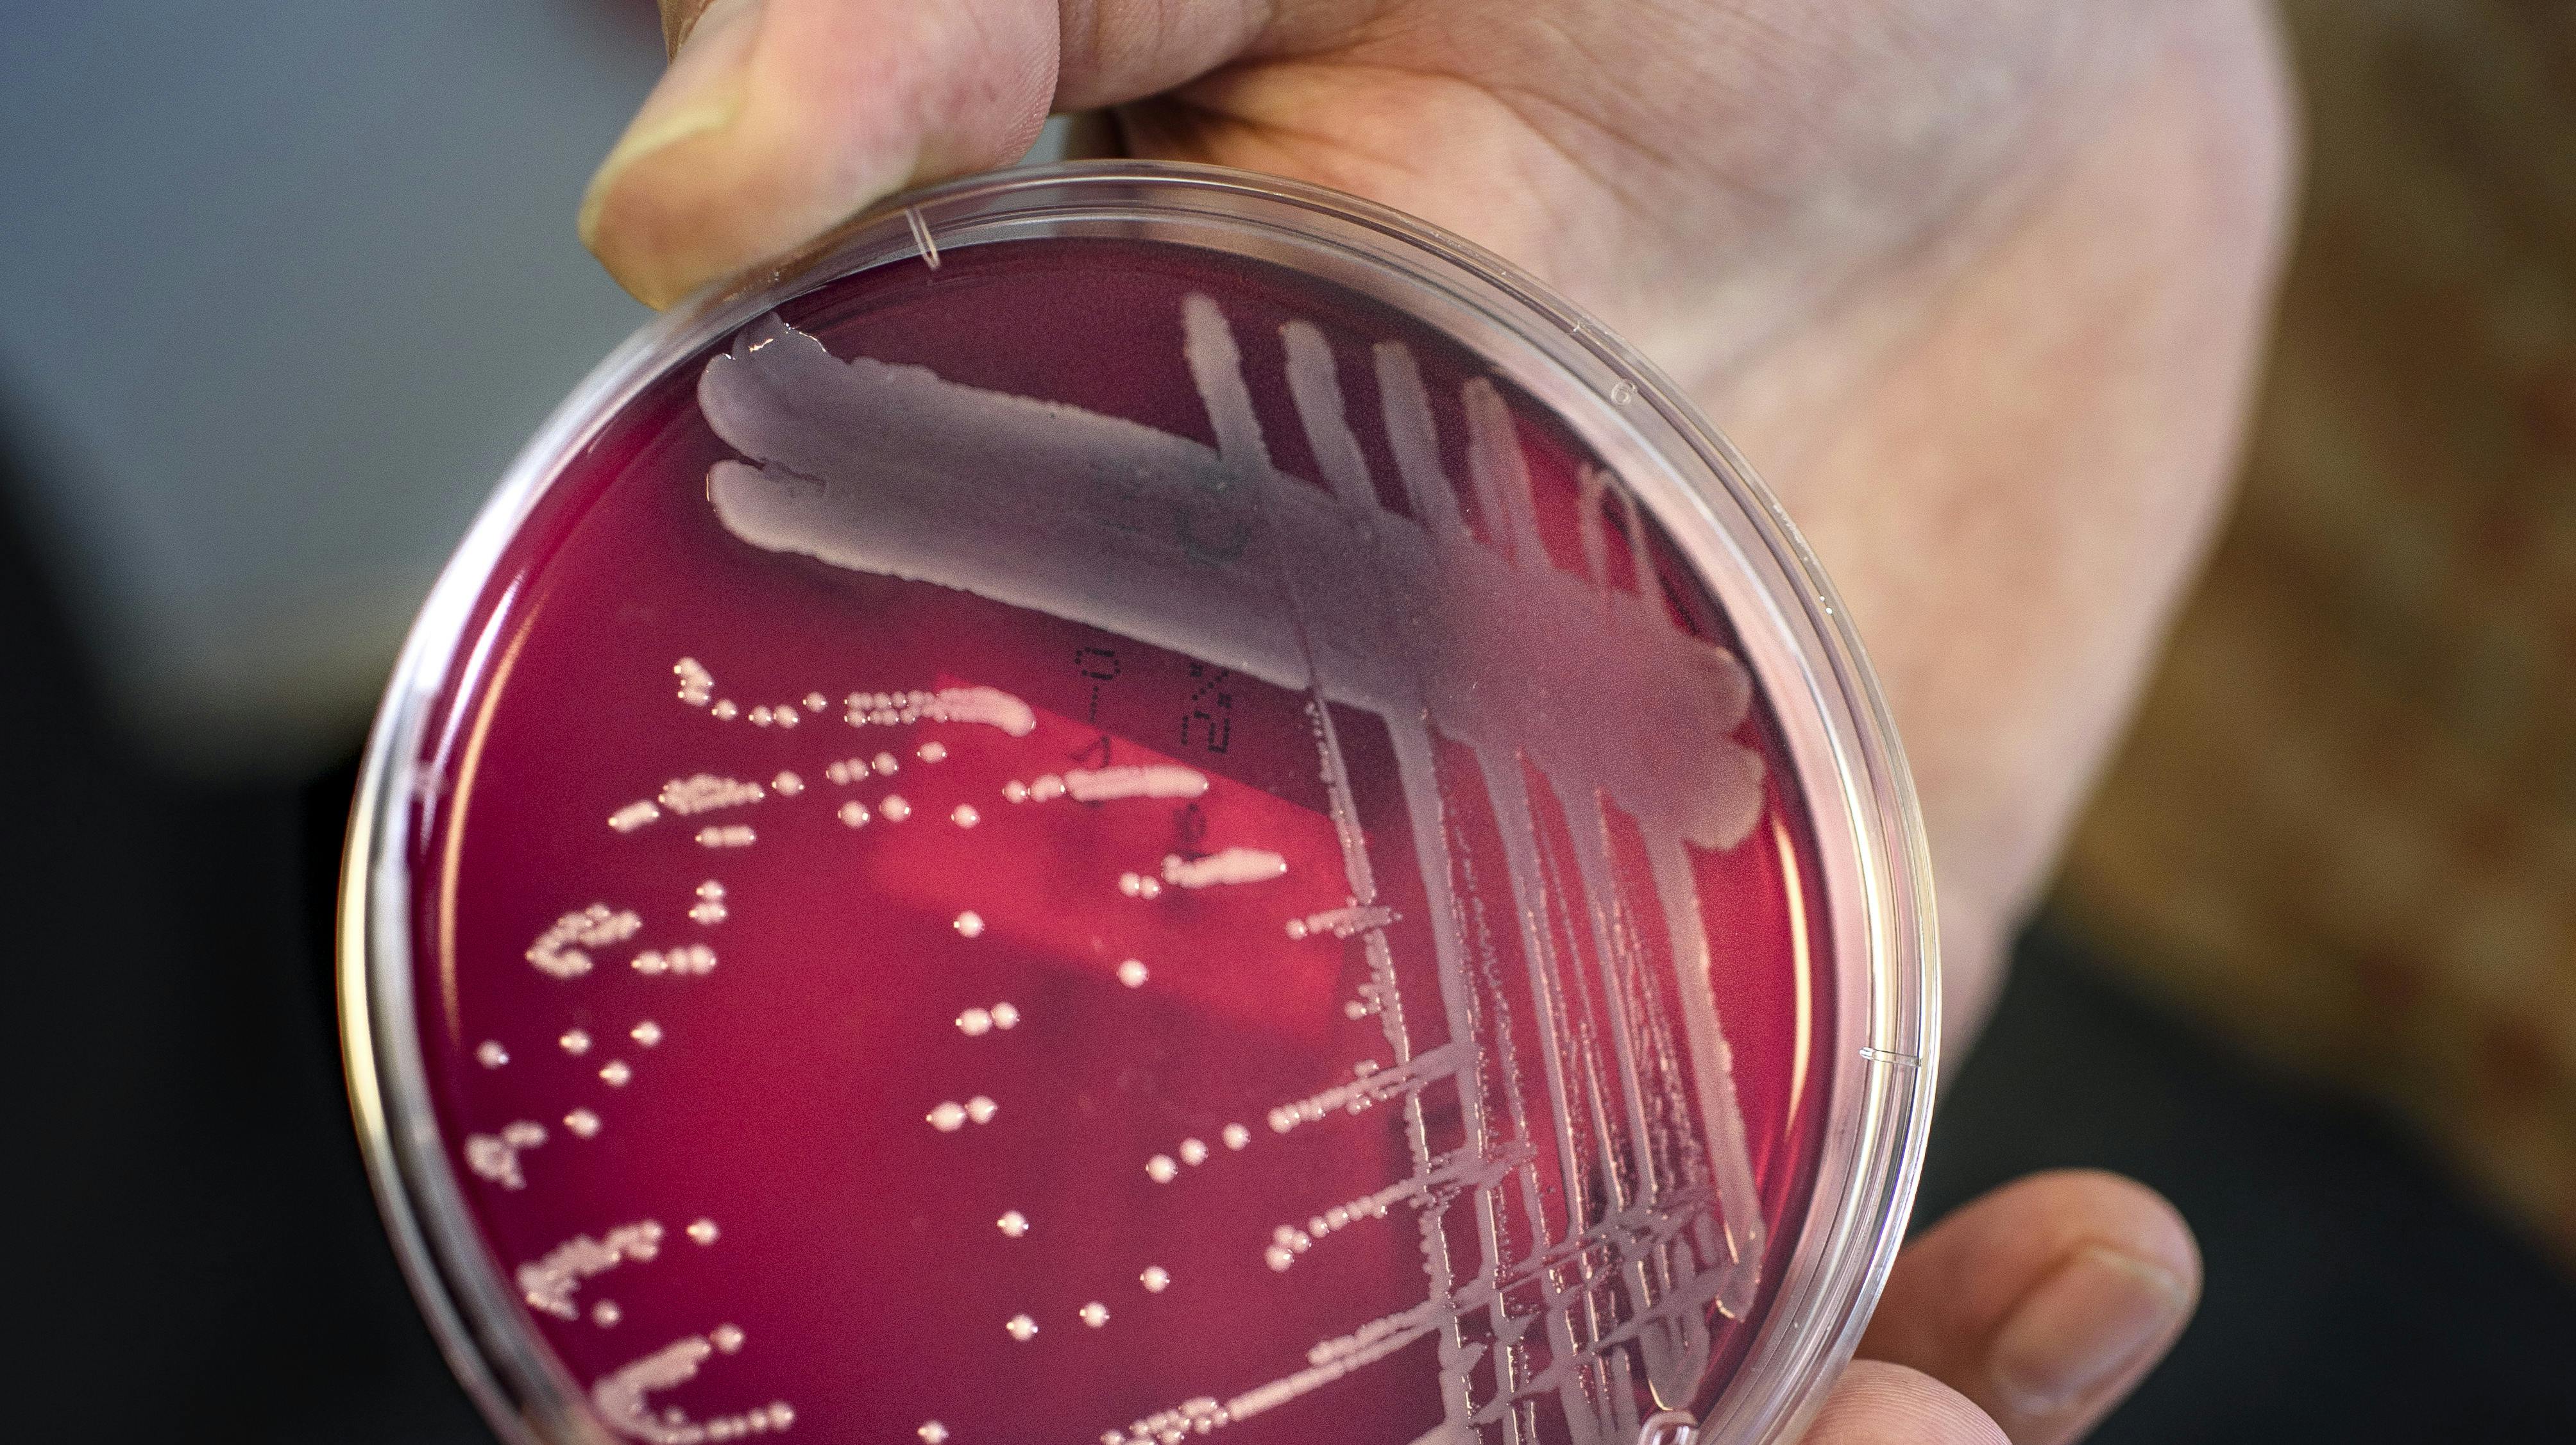
En ny variant af streptokokbakterier ramte Danmark hårdt den forgangne vinter.

Ny variant af streptokokbakterier: Mange danskere blev ramt
Mange danskere blev ramt af streptokokinfektioner den forgangne vinter.
De blev syge med blandt andet halsbetændelse og hudinfektioner.
Nogle blev særligt slemt ramt og fik blandt andet blodforgiftning, svær lungebetændelse, meningitis og led- og muskelinfektioner.
Et nyt studie viser, at en ny variant af streptokokbakterier kombineret med nedsat immunitet i befolkningen efter corona var årsagen.
Det skriver Statens Serum Institut (SSI) på sin hjemmeside.
Den nye streptokokvariant kaldes M1DK og blev opdaget i 2022. Den betegnes af en af forskerne bag studiet, Thor Bech Johannes, som aggressiv.
- Den nye aggressive variant har haft afgørende betydning, men forklarer ikke alle tilfælde, siger han.
- Formodentlig har det også haft stor betydning, at vi igennem de seneste år i langt lavere grad end normalt har været eksponeret for gruppe-A-streptokokker, og dermed har fået en langt lavere grad af immunitet, siger Thor Bech Johannes.
Der var cirka tre til fire gange så mange tilfælde af streptokokinfektioner denne vinter sammenlignet med en normal vinter.
Den nyopdagede variant stod bag næsten hvert tredje invasive tilfælde denne vinter.
De invasive tilfælde er de tilfælde, hvor streptokokker har spredt sig og forårsaget alvorlige tilstande såsom blodforgiftning.
Coronapandemien var ifølge forskerne medvirkende årsag til streptokokbakteriernes fremmarch.
Under nedlukningerne var kontakten til andre mennesker begrænset. Det begrænsede også udvekslingen af sygdomsfremkaldende bakterier.
Da samfundet blev genåbnet, var befolkningens generelle immunitet mod infektioner blevet nedsat.
Den gode nyhed er ifølge forskerne, at vi kan forvente færre streptokokinfektioner den kommende vinter.
- Vi forventer derfor også, at situationen bliver mindre alvorlig næste vinter, da en stor del af befolkningen nu vil have opbygget en højere immunitet, siger Thor Bech Johannes.
Det nye studie er resultatet af et samarbejde mellem seruminstituttet og kliniske mikrobiologiske afdelinger i hele Danmark samt Island.